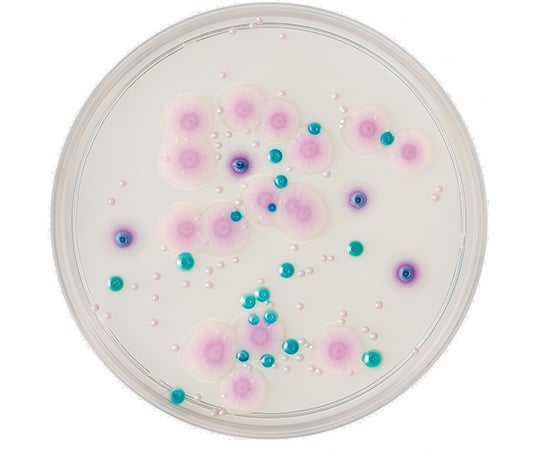
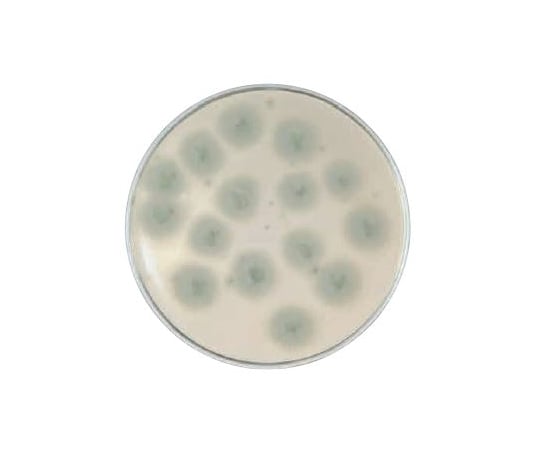

福A【バーゲン 特別価格】ブラジャー 育乳 カシュクールレース 脇高ブラ(R) 単品ブラジャー(下着 女性 ブラ 谷間 育成 脇高 脇肉 セクシー 総レース 痛くない 盛りブラ 盛ブラ 小胸 レディース 育乳ブラ いくにゅうぶら 盛れるブラ 寄せ 上げ 補正下着 補正ブラ 可愛い
2,580円
12771 customer ratings
4.44 ★★★★
カシュクールレース 脇高ブラ(R) カシュクールレース 脇高ブラ(R)セット カシュクールレース 脇高ブラ(R)(FGH) カシュクールレース 脇高ブラ(R)セット(FGH) カシュクールレース 単品ショーツ2 カシュクールレース 総レース 単品ショーツ カシュクールレース…